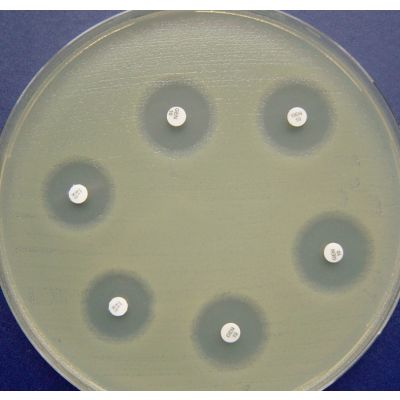
SENSIFAR - 1

SENSIFAR - 1
Fabricante:Cefar

Categorias:Microbiologia
Discos de papel impregnados com antimicrobianos utilizados para avaliação da sensibilidade microbiana in vitro. Produzidos de acordo com os parâmetros estabelecidos pelo CLSI e BrCast. As seguintes opções da linha Sensifar estão disponíveis:
Registro no MS: 101.106.200-58
20.100
Ac. Nalidíxico - CLSI / BrCast | NAL 30
20.101
Ac. Pipemidico | PIP 20
20.102
Amicacina - CLSI / BrCast | AMI 30
20.103
Ampicilina - CLSI | AMP 10
20.104
Amoxicilina | AMO 10
20.105
Amoxicilina + Ac. Clavulânico - CLSI | AMC 30
20.106
Azitromicina - CLSI | AZI 15
20.107
Aztreonam - CLSI / BrCast | ATM 30
20.108
Ampicilina + Sulbactam - CLSI / BrCast | ASB 20
20.109
Ac. Clavulânico. + Ticarcilina - CLSI / BrCast | TIC 85
20.200
Bacitracina | BAC 10
20.301
Cefaclor - CLSI / BrCast | CFC 30
20.302
Cefadroxil - BrCast | CFD 30
20.303
Cefalexina - BrCast | CFE 30
20.304
Cefalotina - CLSI | CFL 30
20.306
Cefazolina - CLSI | CFZ 30
20.307
Cefepima - CLSI / BrCast | CPM 30
20.312
Cefotaxima - CLSI | CTX 30
20.313
Cefoxitina - CLSI / BrCast | CFO 30
20.316
Ceftazidima - CLSI | CAZ 30
20.317
Ceftriaxona - CLSI / BrCast | CRO 30
20.318
Cefuroxima - CLSI / BrCast | CRX 30
20.319
Ciprofloxacina - CLSI / BrCast | CIP 5
20.320
Claritromicina - CLSI | CLA 15
20.321
Clindamicina - CLSI / BrCast | CLI 2
20.322
Cloranfenicol CLSI / BrCast | CLO 30
20.323
Cotrimazina (Sulfadiazima+ Trimetoprima) | SZT 25
20.324
Cotrimoxazol (Sulfatrin) - CLSI / BrCast | SUT 25
20.326
Colisitna - CLSI | COL 10
20.401
Doxiciclina - CLSI | DOX 30
20.500
Eritromicina - CLSI / BrCast | ERI 15
20.501
Ertapenem - CLSI / BrCast | ETP 10
20.502
Estreptomicina - CLSI | EST 10
32.041
Espectinomicina - CLSI | EPT 100
20.550
Fosfomicina - CLSI / BrCast | FOS 200
20.700
Gentamicina - CLSI / BrCast | GEN 10
20.900
Imipenem - CLSI / BrCast | IPM 10
21.200
Lincomicina | LIN 2
21.201
Lomefloxacina - CLSI | LMX 10
21.202
Levofloxacina - CLSI / BrCast | LVX 05
21.203
Linezolida - CLSI | LNZ 30
21.300
Minociclina - CLSI / BrCast | MIN 30
21.302
Meropenem - CLSI / BrCast | MER 10
21.303
Moxifloxacina - CLSI / BrCast | MFX 5
21.400
Neomicina | NEO 30
21.402
Nitrofurantoina - CLSI | NIT 300
21.403
Norfloxacina - CLSI / BrCast | NOR 10
21.500
Ofloxacina - CLSI / BrCast | OFX 5
21.501
Oxacilina - CLSI / BrCast | OXA 1
21.600
Pefloxacina - CLSI / BrCast | PEF 5
21.601
Penicilina G. - CLSI | PEN 10
21.603
Piperacilina + Tazobactan - CLSI | PPT 110
21.602
Polimixina B. - CLSI | POL 300
21.801
Rifampicina (Enterobactérias) | RIF 30
21.802
Rifampicina (Neisseria) - CLSI / BrCast | RIF 5
21.803
Roxitromicina | ROX 15
21.900
Sulfonamidas - CLSI | SUL 300
22.000
Teicoplanina - CLSI / BrCast | TEC 30
22.001
Tetraciclina - CLSI / BrCast | TET 30
22.003
Tobramicina - CLSI / BrCast | TOB 10
22.004
Trimetoprima - CLSI / BrCast | TRI 5
22.100
Vancomicina - CLSI | VAN 30
Resumo
Discos de papel impregnados com antimicrobianos utilizados para avaliação da sensibilidade microbiana in vitro. Produzidos de acordo com os parâmetros estabelecidos pelo CLSI e BrCast. As seguintes opções da linha Sensifar estão disponíveis:
Registro no MS: 101.106.200-58
20.100
Ac. Nalidíxico - CLSI / BrCast | NAL 30
20.101
Ac. Pipemidico | PIP 20
20.102
Amicacina - CLSI / BrCast | AMI 30
20.103
Ampicilina - CLSI | AMP 10
20.104
Amoxicilina | AMO 10
20.105
Amoxicilina + Ac. Clavulânico - CLSI | AMC 30
20.106
Azitromicina - CLSI | AZI 15
20.107
Aztreonam - CLSI / BrCast | ATM 30
20.108
Ampicilina + Sulbactam - CLSI / BrCast | ASB 20
20.109
Ac. Clavulânico. + Ticarcilina - CLSI / BrCast | TIC 85
20.200
Bacitracina | BAC 10
20.301
Cefaclor - CLSI / BrCast | CFC 30
20.302
Cefadroxil - BrCast | CFD 30
20.303
Cefalexina - BrCast | CFE 30
20.304
Cefalotina - CLSI | CFL 30
20.306
Cefazolina - CLSI | CFZ 30
20.307
Cefepima - CLSI / BrCast | CPM 30
20.312
Cefotaxima - CLSI | CTX 30
20.313
Cefoxitina - CLSI / BrCast | CFO 30
20.316
Ceftazidima - CLSI | CAZ 30
20.317
Ceftriaxona - CLSI / BrCast | CRO 30
20.318
Cefuroxima - CLSI / BrCast | CRX 30
20.319
Ciprofloxacina - CLSI / BrCast | CIP 5
20.320
Claritromicina - CLSI | CLA 15
20.321
Clindamicina - CLSI / BrCast | CLI 2
20.322
Cloranfenicol CLSI / BrCast | CLO 30
20.323
Cotrimazina (Sulfadiazima+ Trimetoprima) | SZT 25
20.324
Cotrimoxazol (Sulfatrin) - CLSI / BrCast | SUT 25
20.326
Colisitna - CLSI | COL 10
20.401
Doxiciclina - CLSI | DOX 30
20.500
Eritromicina - CLSI / BrCast | ERI 15
20.501
Ertapenem - CLSI / BrCast | ETP 10
20.502
Estreptomicina - CLSI | EST 10
32.041
Espectinomicina - CLSI | EPT 100
20.550
Fosfomicina - CLSI / BrCast | FOS 200
20.700
Gentamicina - CLSI / BrCast | GEN 10
20.900
Imipenem - CLSI / BrCast | IPM 10
21.200
Lincomicina | LIN 2
21.201
Lomefloxacina - CLSI | LMX 10
21.202
Levofloxacina - CLSI / BrCast | LVX 05
21.203
Linezolida - CLSI | LNZ 30
21.300
Minociclina - CLSI / BrCast | MIN 30
21.302
Meropenem - CLSI / BrCast | MER 10
21.303
Moxifloxacina - CLSI / BrCast | MFX 5
21.400
Neomicina | NEO 30
21.402
Nitrofurantoina - CLSI | NIT 300
21.403
Norfloxacina - CLSI / BrCast | NOR 10
21.500
Ofloxacina - CLSI / BrCast | OFX 5
21.501
Oxacilina - CLSI / BrCast | OXA 1
21.600
Pefloxacina - CLSI / BrCast | PEF 5
21.601
Penicilina G. - CLSI | PEN 10
21.603
Piperacilina + Tazobactan - CLSI | PPT 110
21.602
Polimixina B. - CLSI | POL 300
21.801
Rifampicina (Enterobactérias) | RIF 30
21.802
Rifampicina (Neisseria) - CLSI / BrCast | RIF 5
21.803
Roxitromicina | ROX 15
21.900
Sulfonamidas - CLSI | SUL 300
22.000
Teicoplanina - CLSI / BrCast | TEC 30
22.001
Tetraciclina - CLSI / BrCast | TET 30
22.003
Tobramicina - CLSI / BrCast | TOB 10
22.004
Trimetoprima - CLSI / BrCast | TRI 5
22.100
Vancomicina - CLSI | VAN 30
COMPARADOR
Adicione mais produtos
para comparar